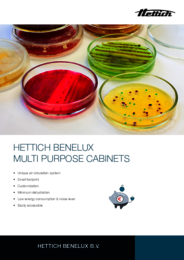

MPC 600
Multi Purpose - Incubator
Kies een product:
Feiten en cijfers
575
Intern volume
4
Aantal legplateaus
71x88,5x201 cm
Buitenmaten bxdxh(1)
RT +8°C tot 55°C
Temperatuurbereik (2)
Hettich Benelux MPC 600
Hettich Benelux ontwikkelt en produceert 'Multi Purpose Cabinets'. Deze kasten kunnen geleverd worden als incubator, gekoelde incubator, koelkast of vriezer. Alle modellen kunnen gecombineerd worden in een wand met panelen tussen kast en plafond voor een stofvrije afwerking. Een model aanpassen aan uw wensen met bijvoorbeeld een glazen deur behoort ook tot de mogelijkheden.
De kasten zijn voorzien van ons unieke 'Vertical Air System', dat minimale uitdroging van uw product garandeert. Met deze techniek combineren we de voordelen van natuurlijke convectie en geforceerde ventilatie. Ventilatoren worden buiten het werkgebied geplaatst, waardoor een zeer lage luchtstroom in de kast ontstaat. Dit zorgt voor een homogeen temperatuurprofiel in de hele kast. Dit wordt voornamelijk vastgehouden door warmtestraling, waardoor 'hot spots' worden voorkomen.
Door dit ontwerp te gebruiken hebben we een maximaal bruikbaar gevalideerd werkgebied gecreëerd. De temperatuur, nauwkeurigheid en homogeniteit zijn gemeten en voldoen aan de DIN 12880:2007-7 richtlijn.
1 Zonder handgreep,diepte met handgreep is 94,2 cm
2 Optioneel 65 °C
Voordelen
Applicaties
- Microbiologisch onderzoek.
- Stabiliteitstesten.
- Korte- en langetermijnopslag van materialen.
- Verouderingsonderzoek.
De juiste accessoires/opties voor dit product
Geperforeerde lade van roestvrij staal 304
Hoogte 35 mm
Uitschuifbare geleiderails
Bestelnr.: 1000.9007
Geperforeerde lade van roestvrij staal 304
Hoogte 100 mm
Uitschuifbare geleiderails
Bestelnr.: 1000.9008
Geperforeerde lade van roestvrij staal 304
Hoogte 150 mm
Uitschuifbare geleiderails
Bestelnr.: 1000.9009
Geperforeerd legplateau van roestvrij staal 304
Inclusief geleiders
Max. gewicht per plateau 50 kg
Oppervlakte 0,32 m²
Bestelnr.: 1000.9010
Dicht legplateau van roestvrij staal 304
Inclusief geleiders
Max. gewicht per plateau 50 kg
Oppervlakte 0,32 m²
Bestelnr.: 1000.9011
Lade van roestvrij staal 304
Hoogte 35 mm
Uitschuifbare geleiderails
Bestelnr.: 1000.9032
Lade van roestvrij staal 304
Hoogte 100 mm
Uitschuifbare geleiderails
Bestelnr.: 1000.9033
Lade van roestvrij staal 304
Hoogte 150 mm
Uitschuifbare geleiderails
Bestelnr.: 1000.9034

Hoe kunnen we u helpen?
Maak uw keuze en stel ons uw vraag.